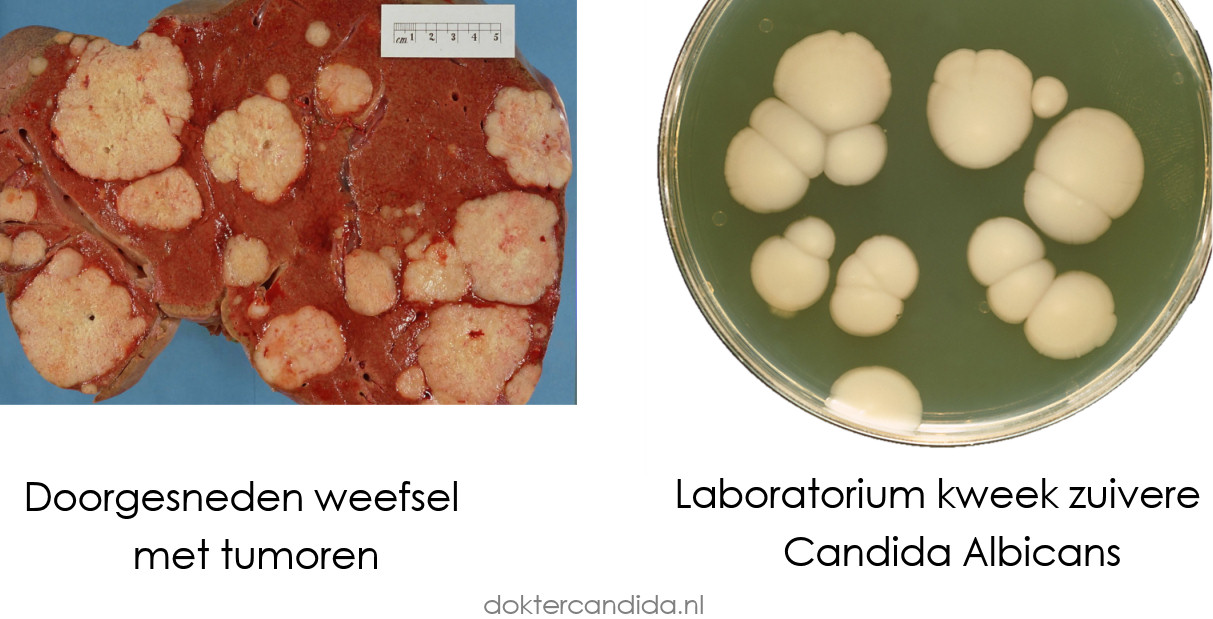
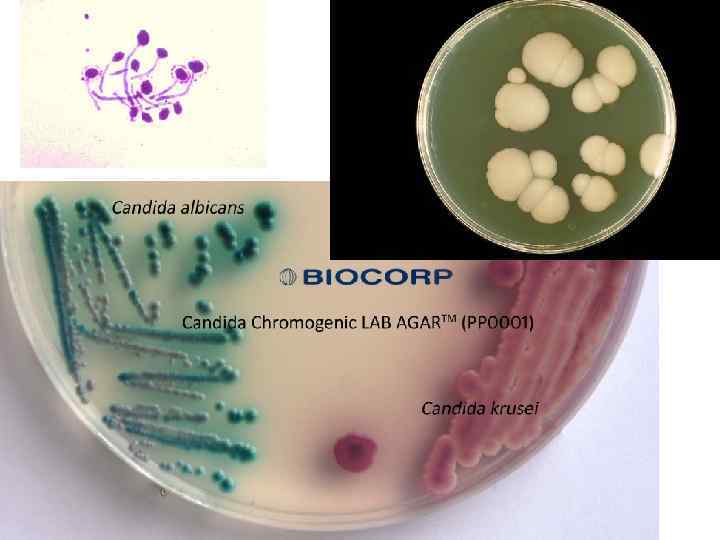

Кандида Альбиканс В Кишечнике

💣 👉🏻👉🏻👉🏻 ИНФОРМАЦИЯ ДОСТУПНА ЗДЕСЬ! КЛИКАЙ 👈🏻👈🏻👈🏻
Купить Ксонеф в Багратионовске
Купить Лоротокс метро Алтуфьево
Купить Ультра-Д в Красноармейске
Купить Клостилбегит в Первомайске
Кандида Альбиканс В Кишечнике


























































































💣 👉🏻👉🏻👉🏻 ИНФОРМАЦИЯ ДОСТУПНА ЗДЕСЬ! КЛИКАЙ 👈🏻👈🏻👈🏻
Купить Ксонеф в Багратионовске
Купить Лоротокс метро Алтуфьево
Купить Ультра-Д в Красноармейске
Купить Клостилбегит в Первомайске
Кандида Альбиканс В Кишечнике